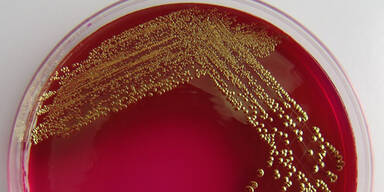
Petrischale

Die Laborgruppe Futurelab erzielte im ersten Halbjahr 2009 mehr Gewinn: Das Konzern-EBITDA stieg verglichen mit dem Vorjahreszeitraum von 13,6 auf 16,1 Mio. Euro. Diese Ergebnisverbesserung sei ausschließlich auf die Kostendisziplin zurückzuführen. Das Vorsteuerergebnis wird mit 9,3 (6,7) Mio. Euro ausgewiesen, der Gewinn nach Steuern mit 6,6 (4,2) Mio. Euro.
Die Umsatzerlöse der in Österreich, Deutschland, der Schweiz sowie in Osteuropa (u.a. Tschechien, Slowakei, Ungarn, Rumänien) tätigen Unternehmensgruppe stiegen auf 66,7 (64,2) Mio. Euro. Futurelab gehört zu 58 Prozent der Duff-Privatstiftung von Geschäftsführer Michael Havel und der Vienna Insurance Group zu rund 42 Prozent.
Laut Halbjahresbericht bearbeiten die rund 1.750 Mitarbeiter der Gruppe täglich die Proben von rund 30.000 Patienten bzw. rund 250.000 Analysen.
Im zweiten Halbjahr seien weitere strukturelle Straffungen, Verschmelzungen, Konditionsverbesserungen im Einkauf etc. geplant. Insgesamt würden daher - trotz einer empfindlich umsatz- und ergebniseingreifenden Tarifreform in der Schweiz - gegenüber dem vorangegangenen Jahr Ergebnisverbesserungen erwartet.